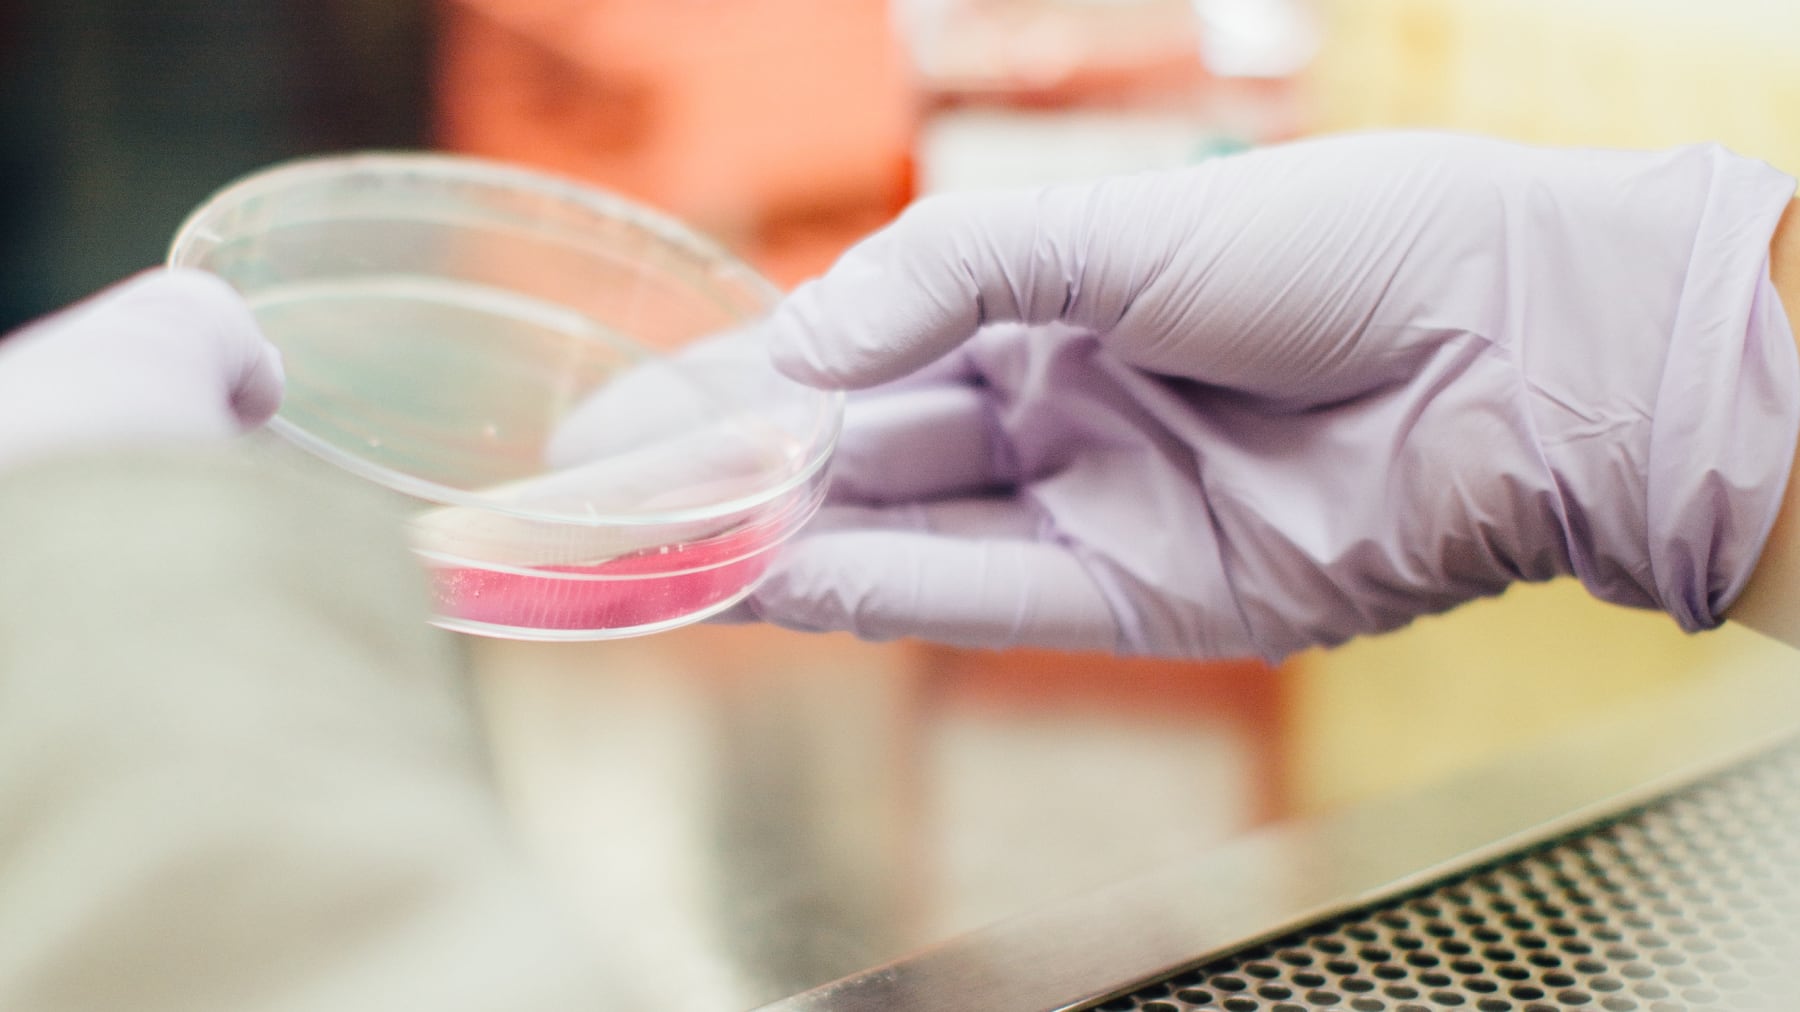

We help hospitals, clinics and other healthcare facilities become more connected, efficient and secure.
Our Capabilities
Lorem ipsum dolor sit amet, consectetur adipiscing elit. Donec ac leo erat. Fusce urna quam, cursus id neque quis, luctus.
Lorem ipsum dolor sit amet, consectetur adipiscing elit. Donec ac leo erat. Fusce urna quam, cursus id neque quis, luctus.
20 words. Lorem ipsum dolor sit amet, consectetur adipiscing elit. Nam interdum erat iaculis dolor hendrerit, id convallis sem cursus. Sed non dolor vitae quam tristique tincidunt.
20 words. Lorem ipsum dolor sit amet, consectetur adipiscing elit. Nam interdum erat iaculis dolor hendrerit, id convallis sem cursus. Sed non dolor vitae quam tristique tincidunt.
20 words. Lorem ipsum dolor sit amet, consectetur adipiscing elit. Nam interdum erat iaculis dolor hendrerit, id convallis sem cursus. Sed non dolor vitae quam tristique tincidunt.
20 words. Lorem ipsum dolor sit amet, consectetur adipiscing elit. Nam interdum erat iaculis dolor hendrerit, id convallis sem cursus. Sed non dolor vitae quam tristique tincidunt.